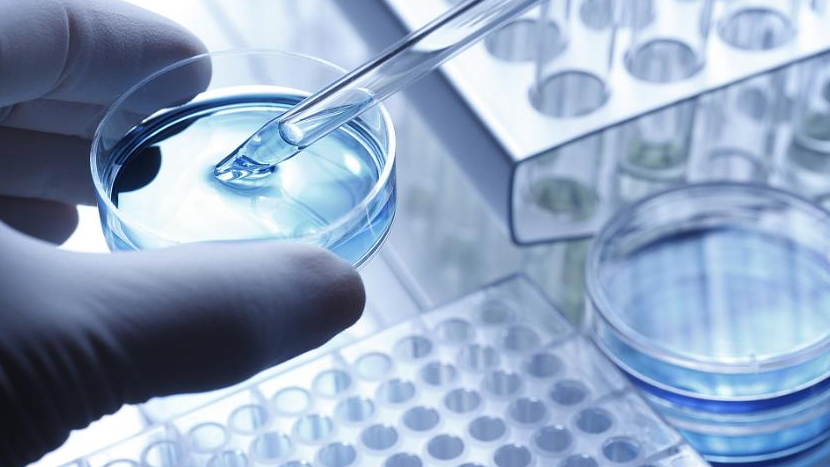

“自热食品”餐后垃圾随意丢存污染隐患
点击量:10061
近年来,“自热米饭”“自热小火锅”等“自热食品”在速食市场热销,颇受年轻消费者欢迎。但记者调研了解到,网红“自热食品”的发热包等包装被随意大量丢弃,存在污染土壤、水等环境隐患,亟待引起警惕和重视。
“自热食品”走红 餐后垃圾被随意丢弃
“自嗨锅”“自热煲仔饭”“即食小火锅”……随着天气越来越冷,可以随时随地吃起来,不用电、不用火、不用锅的“自热食品”成了受青年人追捧的网红食品,畅销网络,也成为疫情居家期间最受消费者欢迎的商品之一。
记者在京东、淘宝等多个网络购物平台上看到,类似“自热食品”销量可观,一款普通的“自热食品”大多售价在20元-40元左右,多款产品销量在1万件以上,不少“自热食品”还登上了购物平台速食回购榜前十名。
“自热食品”为何畅销?记者随机采访了多位消费者,“方便”“不用开火”“不用洗碗”等原因居多。“下了夜班回到家,打开一盒‘自嗨锅’加水就能煮熟,看着电视剧吃完,直接就能丢了,都不用洗碗,太方便了。”在成都高新区软件行业工作的李女士说。
成都餐饮同业公会秘书长袁小然介绍,“自热食品”一般分两层,上层是肉类、米饭等食材,下层是一个发热包,其主要成分是焙烧硅藻土、铁粉、铝粉、生石灰、碳酸钠等,发热包中的生石灰遇水发热,转化成熟石灰,在这个过程中释放热能并产生水蒸气,从而煮熟食物。购买“自热食品”的大多数为年轻人,他们大多忙于工作,生活压力大,无暇做饭,也不愿意多花时间做家务,简单加水就能“煮熟”的“自热食品”正好切中当下年轻人的即时就餐需求。
四川省食品检验研究院工程师闵宇航介绍,“自热食品”上层的食材在丢弃时可以按照生活垃圾处理,但是下层的发热包不能随意丢弃,因为“自热食品”加热完之后,生石灰变成了熟石灰,熟石灰具有腐蚀性,如果把相当量的熟石灰扔到环境中,会对环境产生影响。
当前,“自热食品”垃圾大量随意丢弃已成为普遍现象。记者走访成都多个小区后发现,很多人把“自热食品”作为一般垃圾扔在了垃圾箱里。“吃完就直接扔垃圾桶了,包括下面的发热包,全当厨余垃圾一样扔了,我也困惑发热包到底属于什么垃圾。”成都市民夏女士说。
环境污染隐患不容忽视
记者调研了解到,近年来,大家比较关注的是“自热食品”的“自燃”危害,但对其发热包等可能导致的环境污染隐患缺乏警惕,背后也暴露出标准缺失、管理盲区等漏洞。
目前,“自热食品”垃圾丢弃缺乏规范。记者调研了解到,虽然多地已经推行垃圾分类,但对于“自热食品”等新兴产品产生的垃圾丢弃,还缺乏相应的规范。闵宇航等专家认为,“自热食品”不仅包括了半成品食材,还包括了“厨具”和“燃料”。尽管这个“厨具”和“燃料”很简单,但它有热源,也有加热设备。从本质上说,“自热食品”相当于“大米+电饭锅+电源”或者“肉+铁锅+酒精炉”的组合。对它的安全性和环境影响的评估,需要综合考虑到食物和“厨具”,但目前还没有专门的规范出台,所以一般是把其作为食物类垃圾来丢弃,并没有考虑发热包等厨具被丢弃后对环境的影响。
部分“自热食品”生产加工时也缺乏环境保护的标准设计。一些食品行业的业内人士透露,“自热食品”在生产时主要是考虑到方便自热、口感等指标,对于加热包内的“燃料”含量多少,是否会对环境存在长期污染等,缺乏行业标准设计。
闵宇航等专家提醒,目前市面上“自热食品”的包装多数为聚丙烯塑料包装,该包装价格较低且供应充足,具有相对良好的机械性能、阻隔性能和热封性能,但并非完全可回收,也不可降解,随意丢弃后可能会对环境造成污染。
在监管方面,“自热食品”按食品类别来监管,也存在一些监管盲区。采访中,部分业内人士告诉记者,当下,“自热食品”还是由各地市场监管部门按照食品类来监管的,主要是看其安全性、卫生等是否存在问题,对“自热食品”被随意丢弃的环境问题等存在监管盲区。
闵宇航等专家介绍,在工业生产中,危险品的存放和使用是有严格的操作规范的,运输过程也需要特别的运输工具。而带着自热袋的“自热食品”却是作为食品通过电商平台来销售的。在食品生产中有规定,高酸性和高碱性的废物不能直接丢弃或者排放,“自热食品”垃圾中也存在高酸性和高碱性物质,可以算“有害垃圾”,但却长期被当作一般垃圾随意扔掉,其中的物质堆积得多了,有可能造成土壤酸碱度失衡。加热包在丢弃时,由于含有金属元素及大量碱性化合物,有可能反应不完全, 有二次放热的风险。
亟待完善行业规范和标准
借着“宅经济”风口,“自热食品”这一新兴品类逐渐风靡。专家和业内人士认为,“自热食品”作为新兴流行事物,其环境污染问题不容小视,亟待加快完善相关规范和标准。
一些接受采访的专家呼吁,对于“自热食品”的垃圾分类需要制定细致的标准,比如,加热之前,生石灰有放热的风险,加热包应属于有害垃圾;加热反应结束后的加热包则是干垃圾,也可属于其他垃圾。正确进行垃圾分类,才能减少环境污染问题,在这方面应该加强宣传和科普。
当前,“自热食品”市场规模增速较快。中国食品工业协会数据显示,2021年我国“自热食品”市场规模达45亿元,同比增长7.14%。记者梳理发现,“自热食品”虽然受到追捧,但是在《食品生产许可分类目录》中还没有“自热食品”这一分类,也反映了这一市场缺乏国家标准、准入门槛相对较低。
多位业内人士呼吁,现有的“自热食品”产业标准体系已经不能完全满足产业快速发展的需要,应加快构建科学实用的“自热食品”标准体系,进行产业引导和约束。“标准体系建设主要包括基础标准、质量安全标准、检测方法标准、产品标准、食品用加热包标准等。”闵宇航说。
有专家还指出,“自热食品”使用完后残留的、未反应完全的化学物质带来的环境污染隐患,也需要引起警惕,在这方面,当下还缺乏研究。
一些业内人士也呼吁,对于“自热食品”生产企业而言,相关部门可以积极引导企业通过产品绿色设计升级,不仅让安全性更有保障,让行业发展更加绿色健康,设计携带方便、加热便捷、绿色环保的包装是行业的一大发展方向。“采用天然、绿色的包装材质和技术,可以提升‘自热食品’行业的公众形象并提高消费者的忠诚度。”袁小然说。
记者 董小红
免责声明:凡本网注明“来源:XXX(非驻马店广视网、驻马店融媒、驻马店网络问政、掌上驻马店、驻马店头条、驻马店广播电视台)”的作品,均转载自其它媒体,转载目的在于传递更多信息,并不代表本网赞同其观点和对其真实性负责,作品版权归原作者所有,如有侵犯您的原创版权请告知,我们将尽快删除相关内容。凡是本网原创的作品,拒绝任何不保留版权的转载,如需转载请标注来源并添加本文链接,否则承担相应法律后果。
来源 / 经济参考报
责任编辑 / 张雪凝
审核 / 李俊杰 刘晓明
终审 / 平筠
-
新冠病毒感染者居家期间生活垃圾怎么处理?指引来啦
健康 2023-01-21 -
打着“纳米”旗号的日用品,是智商税吗
健康 2023-02-10 -
为基层医院培养并留住“好医生”
健康 2023-02-10 -
我国专家提出鼻咽癌放疗新技术 有助减少毒副反
健康 2023-02-10 -
大鱼大肉吃成营养不良 儿童营养门诊医生支招
健康 2023-02-10 -
儿童青少年生长迟缓怎么办?从这份指南看解答
健康 2023-02-09